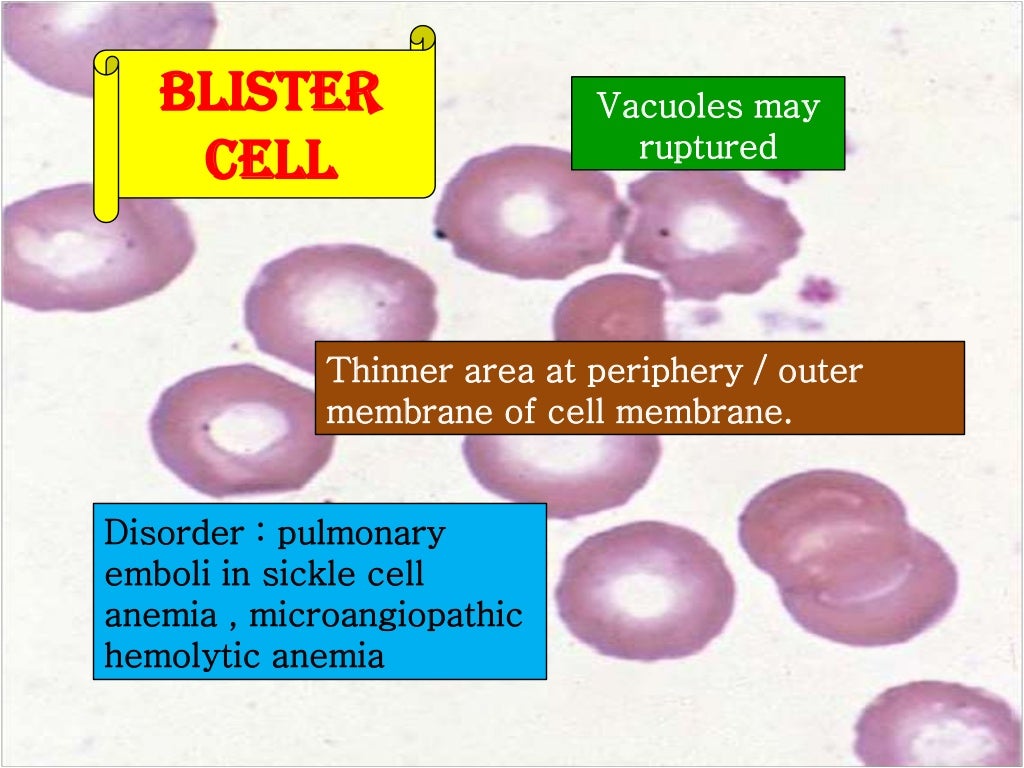

What is the medical term meaning immature white blood cell?
What In Medical Terms Is Absolute Immature Granulocytes? A mature granulocytes is white blood cell that has not yet reached adolescence. Although no sign of an infection can be seen on a complete blood counts test even if you have not contracted an infection, immature granulocytes are absent without their presence on a blood test report.
Is my white blood cell count too high?
Your white blood cell count can be affected by race and any existing health condition. However, the general consensus is that a normal range is between 4,500 to 10,000 white blood cells per cubic millimeter. Any WBC count higher than 11,000 white blood cells per cubic millimeter is considered high.
What causes low white blood count?
These include:
- Infection: Widespread infection can cause a low WBC count, including viral infections and conditions such as HIV. ...
- Damage to bone marrow: This damage may happen due to an infection, a condition, or a medical treatment, such as chemotherapy.
- Cancers that affect the bone marrow: Such cancers include leukemia and multiple myeloma.
Are white blood cells big or small?
White Blood Cells are usually bigger than red blood cells and platelets. However, their most important difference is that White Blood Cells are the only ones having a nucleus. That is the way a doctor can distinguish the ones from the others using the electron microscope when examining your blood specimens.

What does immature white blood cells mean?
A "left shift" is a phrase used to note that there are young/immature white blood cells present. Most commonly, this means that there is an infection or inflammation present and the bone marrow is producing more WBCs and releasing them into the blood before they are fully mature.
Which disease is caused by too many immature white blood cells?
Myelodysplastic syndrome (MDS) is a condition affecting the white blood cells in your bone marrow. The body produces too many immature cells, called blasts. The blasts multiply and crowd out the mature and healthy cells.
What causes immature blood cells?
In a healthy person, bone marrow makes new, immature blood cells that mature over time. Myelodysplastic syndromes occur when something disrupts this process so that the blood cells don't mature. Instead of developing normally, the blood cells die in the bone marrow or just after entering the bloodstream.
What are the immature cells?
An immature cell that can develop into all types of blood cells, including white blood cells, red blood cells, and platelets. Blood stem cells are found in the peripheral blood and the bone marrow. Also called hematopoietic stem cell.
What were your first signs of leukemia?
SymptomsFever or chills.Persistent fatigue, weakness.Frequent or severe infections.Losing weight without trying.Swollen lymph nodes, enlarged liver or spleen.Easy bleeding or bruising.Recurrent nosebleeds.Tiny red spots in your skin (petechiae)More items...•
What blood tests show leukemia?
A complete blood count (CBC) is a common blood test that your doctor may recommend to: Help diagnose some blood cancers, such as leukemia and lymphoma....A CBC measures the amount of 3 types of cells in your blood:White blood cell count. ... White blood cell differential. ... Red blood cell count. ... Platelet count.
What is the WBC count in leukemia?
At the time of diagnosis, patients can have very, very high white blood cell counts. Typically a healthy person has a white blood cell count of about 4,000-11,000. Patients with acute or even chronic leukemia may come in with a white blood cell count up into the 100,000-400,000 range.
How long before MDS turns into leukemia?
The WHO Prognostic Scoring System (WPSS) risk groups can also be used to predict outcome – both median survival and the chance that the MDS will transform into acute myeloid leukemia (AML) within 5 years.
Does MDS always turn into leukemia?
In the past, MDS was sometimes referred to as pre-leukemia or smoldering leukemia. Because most patients do not get leukemia, MDS used to be classified as a disease of low malignant potential.
Why are immature cells important?
Red blood cells are released into the blood stream in their immature form—reticulocytes—from the bone marrow where they develop. Reticulocytes are important markers for certain blood disorders and infectious diseases but their maturation has been poorly understood.
What is the difference between mature and immature cells?
Mature lymphocytes have the ability to fight against infection in the body, while immature lymphocytes lack the ability to fight against infection in the body. Thus, this is the key difference between mature and immature lymphocytes.
Are neutrophils immature white blood cells?
Immature neutrophils are a type of white blood cell (neutrophil) that have not fully matured. Neutrophils are the most common type of white blood cell. Like all white blood cells, they are involved in fighting infection and healing from injury and disease.
What happens if you have too many white blood cells?
A high white blood cell count may indicate that the immune system is working to destroy an infection. It may also be a sign of physical or emotional stress. People with particular blood cancers may also have high white blood cells counts.
What diseases affect white blood cells?
A number of diseases and conditions may affect white blood cell levels:Weak immune system. This is often caused by illnesses such as HIV/AIDS or by cancer treatment. ... Infection. ... Myelodysplastic syndrome. ... Cancer of the blood. ... Myeloproliferative disorder. ... Medicines.
What are the disorders of white blood cells?
Two major types of white blood cell disorders are proliferative disorders and leukopenias. In the proliferative disorders, there is an increase in the number of white blood cells. This increase is commonly a reaction due to infection, but may, less commonly, be related to some types of cancer.
What happens if you have too little white blood cells?
A low white blood cell count in adults is less than 4,000 cells per microliter of blood. A low white blood cell count can be an indicator of certain conditions, including lupus, rheumatoid arthritis, vitamin deficiencies, or a side effect of cancer treatment.
Why do I have immature granulocytes in my peripheral blood?
With the exception of blood from neonates or pregnant women, the appearance of immature granulocytes in the peripheral blood indicates an early-stage response to infection, inflammation or other stimuli of the bone marrow.
What is a high count of immature granulocytes?
More than 2% immature granulocytes is a high count.
Why is the immature granulocyte count important?
As a marker for children: The immature granulocytes count of children, especially premature neonates or neonates younger than seven days, has to be taken with care due to their immature immune systems and the greater number of immature cells in the circulating blood.
What does it mean when a granulocyte count is increased?
They may already have a suppressed immune system. When this test is run, if the result shows an increase, it means that the immune response will be severe.
What is the best result for a granulocyte count?
Optimal Result: 0 - 0.5 %. Immature granulocytes are white blood cells that are immature. Small amounts of white blood cells may be present on a complete blood count test whether or not you have an infection although healthy people do not show immature granulocytes on their blood test report. However, whenever your body is fighting an infection, ...
Can granulocyte count predict sepsis?
The immature granulocytes count alone does not let you predict sepsis (= when your body has an unusually severe response to an infection) or infection. However, it can support diagnosis and prediction together with other parameters such as cytokines, interleukins and CRP.
Is low granulocyte count bad?
There is no health issue associated with low granulocyte counts.
What are white blood cells?
Fight infections: White blood cells are the cells in our body that fight infections. There are five types of white blood cells: lymphocytes, neutrophils, monocytes, eos... Read More
What type of cells are found in acute leukemia?
Acute leukemia: Immature white blood cells called blast cells are found in acute leukemia- both in acute lymphoblastic and myelogenous leukemia. It also can be seen i ... Read More
Are there many different reasons for premature white blood cells?
Unclear question: Premature white blood cells is not a recognized medical term. If you mean immature white blood cells, there are many reasons for that, including infec... Read More
Can you clone white blood cells?
Yes.: A bone marrow transplant is essentially collecting the stem cells that grow into white cells red cells and platelets and then giving them to a recipie... Read More
What is the name of the drug that is used to treat acute leukemia?
Imatinib: Acute leukemia is a malignancy of immature WBC that are normally in the bone marrow in low numbers. Imatinib (Gleevec) is an enzyme inhibitor drug tha... Read More
Is a white blood cell normal?
Blood cancer or tx: Immature white blood cells can be normal if they are located in the blood factory ( bone marrow ) and lead to further blood development. If the blood ... Read More
Can you tell me about immature white blood cells, lymphocytic or myeloid?
Source of cell.: WBCs are derived from a common stem cell, but early on in development they branch. One way leads to lymphocytes, the immune cells involved with adapt... Read More
What is the cause of white blood cell disorder?
White blood cells, also known as leukocytes , are one of four types of cells that make up blood. They are produced in the bone marrow and play an important role in your immune system. 1
What causes a large number of white blood cells?
Leukocytosis: This is an increased number of white blood cells. Possible causes include bacterial or viral infections, certain medications, allergies, smoking, inflammatory diseases, autoimmune disorders, a genetic condition, and cancer. 3 . Leukemia: This is a cancer of the cells that produce white blood cells in the bone marrow.
What is it called when the body stops producing enough blood cells?
Aplastic anemia: A rare condition in which the body stops producing enough new blood cells
What is the term for a decrease in white blood cells?
Leukopenia: A decrease in white blood cells, which can be caused by cells being destroyed or by not enough cells being made 2
What are the symptoms of WBC?
Symptoms, when they occur, are predominantly related to infection and include: 1 . Frequent or recurrent infections.
How many types of white blood cells are there?
There are also five major types of white blood cells, each of which has a specific function: 1
Why do we need a bone marrow biopsy?
Since white blood cells are produced in the bone marrow, a bone marrow biopsy may also be ordered to get a sample of tissue for evaluation by a pathologist. 3
Where are white blood cells produced?
Like all blood cells, white blood cells are produced primarily in the bone marrow. They develop from stem (precursor) cells that mature into one of the five major types of white blood cells: Neutrophils. Lymphocytes. Monocytes.
What is the function of white blood cells?
Overview of White Blood Cell Disorders. White blood cells (leukocytes) are an important part of the body’s defense against infectious organisms and foreign substances ( the immune system ). To defend the body adequately, a sufficient number of white blood cells must receive a message that an infectious organism or foreign substance has invaded ...
What is non-Hodgkin lymphoma?
Non-Hodgkin lymphomas are a group of cancers that develop in white blood cells known as lymphocytes. Although there are more than 50 different disorders that can be called non-Hodgkin lymphoma, doctors sometimes group them into two broad categories: indolent lymphomas and aggressive lymphomas.
Why do white blood cells increase?
However, an increase in the number of white blood cells is also caused by cancers of the bone marrow (such as leukemia) with the release of immature or abnormal white blood cells from the bone marrow into the blood. Some white blood cell disorders involve only one of the five types of white blood cells. Lymphocytic leukocytosis is an abnormally ...
How many white blood cells are in a microliter?
The total white blood cell count normally ranges between 4,000 and 11,000 cells per microliter (4 to 11 × 10 9 per liter). The proportion of each of the five major types of white blood cells and the total number of cells ...
How do white blood cells defend the body?
To defend the body adequately, a sufficient number of white blood cells must receive a message that an infectious organism or foreign substance has invaded the body, get to where they are needed, and then kill and digest the harmful organism or substance (see figure Lymphatic System: Helping Defend Against Infection ).
What is the term for an abnormally low number of neutrophils, a type of white blood cell in the?
Neutropenia is the term for an abnormally low number of neutrophils, a type of white blood cell in the blood. Which of the following is often the first indication that a person has neutropenia?
What is the role of white blood cells in the immune system?
White blood cells are an important part of your body’s immune system. They’re responsible for protecting your body against infections and invading organisms. You have five types of white blood cells:
What are the conditions that require WBC?
Your doctor may request a WBC count and differential if they suspect you have one of several conditions, including: anemia. infection. leukemia. Both tests can help your doctor determine if your symptoms are due to high or low WBC levels, which will help them understand what condition you may have.
What is differential WBC?
A differential can also detect immature white blood cells and abnormalities, both of which are signs of potential issues. A WBC count can also be called a leukocyte count, and a WBC differential can also be called a leukocyte differential count. Read more: WBC (white blood cell) count ».
How long do you have to wait for WBC results?
Depending on which tests your doctor ordered, you may have to wait several days for results. A single WBC count or differential test doesn’t tell the whole story of what’s going on in your body. However, both tests are important tools that help your doctor find out what might be causing your symptoms.
What are the different types of cells that are affected by a disease?
neutrophils. lymphocytes. monocy tes. eosinophils. basophils. Each of these can be affected in different ways if you have a particular condition or disease. A white blood cell (WBC) count measures the number of white blood cells in your blood, and a WBC differential determines the percentage of each type of white blood cell present in your blood. ...
What causes a decrease in lymphocytes?
viral infection, such as the mumps or measles. A decrease in lymphocytes may be caused by: chemotherapy. HIV infection. leukemia. sepsis. radiation exposure, either accidental or from radiation therapy. An increase in monocytes may be caused by: chronic inflammatory disease.
Can you get another WBC test?
Your doctor will go over the test results with you and, if need be, come up with a treatment plan suited specifically for you. You may need to have more tests performed to confirm a diagnosis, and you may need to get another WBC count and differential in the near future. Last medically reviewed on June 6, 2017.